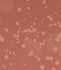

Weihnachten ist immer schneller da, als wir denken. Vielleicht wollen wir es nicht wahrhaben, dass mit Weihnachten auch schon wieder ein Jahr vergangen ist. Vielleicht ist es auch die unterbewusste Sorge, um das richtige Weihnachtsgeschenke zu finden. Dass wir schenken und beschenkt werden, ist für uns selbstverständlich - nicht nur zu Weihnachten. Aber warum tun wir das? Psychologen sagen: Weil wir müssen. Hirnforscher ergänzen: Weil es uns glücklich macht. Haben wir uns einmal überlegt, warum wir uns in volle Einkaufsstraßen drängen, uns durch verstopfte Weihnachtsmärkte zwängen oder uns durch gefühlt 1.000 Internetseiten klicken? Wenn wir diese Frage einem Psychologen oder Verhaltensforscher stellen, kann die Antwort lauten: Weil wir müssen! Die klassische Geschenke-Theorie sagt: Schenken ist universell. Es dient dazu Beziehungen zu stärken. Und dazu gehört auch, dass das Geschenk angenommen wird – wie hässlich es auch immer ist. Genaugenommen schenken wir alle zu wenig! Wenn wir nur zu besonderen Anlässen etwas schenken, ist das jedes Mal ein großer Akt. Wenn wir unserem Nächsten immer wieder ein bisschen etwas schenken, bleibt die Kommunikation dauerhaft lebendig. Wer ein Geschenk bekommt, hat das Bedürfnis, etwas zurückzugeben. Denn das Besondere an Geschenken ist ja, dass man etwas bekommt, ohne dafür etwas getan zu haben. Forscher konnten anhand von Gehirnaktivitäten eindeutig belegen, dass Großzügigkeit unser Wohlbefinden steigert, uns also glücklicher machen kann. Seien Sie auch mit sich selbst großzügig. Schenken Sie sich mehr Zeit für Ruhe.

Mit dieser letzten Ausgabe des Jahres 2022 möchte ich mich herzlich bei Ihnen bedanken. Bedanken für die wohltuenden Anerkennungen für unser Bemühen, Ihnen alle zwei Wochen eine Zeitung mit interessanten Artikeln und auch Werbeangeboten zu bietet.
Verbringen Sie eine friedvolle Weihnacht und möge Ihnen Gesundheit und Zufriedenheit im neuen Jahr beschieden sein!
THEMA 04 | Mit allen Sinnen STRASSENGESCHICHTEN 08 I Vier Steine, ein Land ANGESAGT 15 I EuregioFamilyPass ... STANDORT 19 I Lanas Industriezone und das Naherholungsgebiet DORFGESCHEHEN 22 I „Hoffen kann ich mir nicht mehr leisten“ WANDERN 24 I Ab in den sonnigen Süden! ANZEIGER 26 – Burggräfler Zeitschrift . 39011 Lana . Industriestr. 1/5 Tel. 0473 23 30 24 . Fax 0473 23 57 09 . www.diebaz.com . baz@bezirksmedien.it Redaktionsanschrift: Bezirksmedien GmbH . Telefon 0473 23 30 24 . Fax 0473 23 57 09 . E-Mail: redaktion@diebaz.com Ermächtigung des Landesgerichts Nr. 19/93 . Eintragung im ROC Nr. 3226/1994 Verantwortlich im Sinne des Pressegesetzes: Josef Laner Koordination: Claudia Kaufmann, claudia@diebaz.com Redaktionsleitung: Josef Prantl, Tel. 340 2306888, josef.prantl@fastwebnet.it Mitarbeiter: Christl Fink, Philipp Genetti, Michael Andres, Martin Geier, Walter Werth, Christian Zelger, Markus Auerbach, Wilfried Mayr Werbeverkauf: Claudia Kaufmann, Tel. 347 974 42 70 . claudia@diebaz.com Sonja Trogmann, Tel. 335 839 94 00 . sonja@diebaz.com Grafik und digitale Druckvorstufe: Fotolitho Lana Service, info@fll.it Druck: Athesia Druck GmbH . Weinbergweg 7 . 39100 Bozen

Gender Hinweis: Aus Gründen der besseren Lesbarkeit wird bei Personenbezeichnungen und personenbezogenen Hauptwörtern die männliche Form verwendet. Entsprechende Begriffe gelten im Sinne der Gleichbehandlung grundsätzlich für alle Geschlechter. Die verkürzte Sprachform hat nur redaktionelle Gründe und beinhaltet keine Wertung.



Weltweite Ärztewahl ohne Wartezeiten
Unlimitierte Deckung der Krankenhaus- und Operationskosten, auch ambulant Gratis-Gesundheitscheck, freiwillig alle 2 Jahre und vieles mehr Preislich Top z. B. 42 € monatlich (31 Jahre)
„Wer nicht etwas Zeit für seine Gesundheit aufbringt, wird eines Tages viel Zeit und Geld für die Krankheit opfern.“
Kundenberater Hofer Alexander

Naturns, Hauptstr. 71, T 0473 668277, 8.00 -12.30 Uhr, 15.00-18.00 Uhr Meran, Gampenstr. 97/Q, T 0473 449 344, 8.00 -17.00 Uhr



Langsam wird es Zeit, dass ich meine Weihnachtskrippe hervorhole. Ich freue mich, die wunderbaren Figuren, die meine Mutter vor langer Zeit bei einem Grödner Schnitzer gekauft hat, aus dem Schrank zu holen. Keine große Arbeit, die paar Figuren aufzustellen; Erbstücke, die mir ans Herz gewachsen sind, vor allem aber auch Erinnerungen.
 von Josef Prantl
von Josef Prantl
bereits am 1. Dezember komplett fertig. Andere beginnen am Ersten Advent und lassen die Heilige Familie erst am 24. Dezember in den Stall einziehen. Die einen haben ein Dutzend Figuren, andere mehrere hundert, die sie mit 4 BAZ 23/22

viel Fantasie und Fleiß aufstellen. Jede Weihnachtskrippe ist so individuell wie ihre Besitzer. „Wer einmal mit dem Krippenbauen beginnt, wird in seinen Bann gezogen“, sagt Michael Horrer. THEMA

Der Sekretär von Bischof Ivo Muser ist nicht nur leidenschaftlicher Krippenbauer, sondern auch der Vorsitzende der Südtiroler Krippenfreunde, ein Verein mit rund 1100 Mitgliedern im ganzen Land.
Die Krippe bringt uns zum Nachdenken

„Gott ist Mensch geworden“, so lautet die zentrale Botschaft des Weihnachtsfestes. Weihnachtskrippen setzen sie konkret ins Bild. „Krippendarstellungen sind nicht nur Spielereien, sondern vor allem Orte der Verkündigung: von der Geburt Jesu in einer Futterkrippe, von den Engeln, Hirten, den Heiligen Drei Königen, einem Stern, von Ochs, Esel und Schafen, welche die Botschaft von der Geburt des Messias verkünden. „Jede Figur hat ihren Sinn, eine Bedeutung“, erklärt Michael Horrer. Es gibt sie weltweit: Krippen aus Tansania, vom Titicacasee oder aus Tirol. Die Weihnachtsbotschaft wird in unzähligen Ländern in den unterschiedlichsten Darstellungen bildhaft dargestellt. Das Wort „Krippe“ ist uns als Futterkrippe oder Kinderkrippe geläufig. Vom Ursprung her bedeutet das althochdeutsche Wort „Flechtwerk“, gemeint war der geflochtene Trog. Später wurde dann der erhöhte Futterplatz für Pferde und andere Tiere so bezeichnet. Weniger bekannt ist, dass es neben den Weihnachtskrippen auch Fasten- und Osterkrippen, sogar Jahreskrippen gibt. Sie erzählen die Evangelien nach, bildhaft, anschaulich, mit allen Sinnen erfahrbar.


1979 wurde im Kloster Muri Gries in Bozen der Verein der Südtiroler Krippenfreunde ge-



gründet. Heute gehören ihm 28 Ortsgruppen und weit über 1000 Mitglieder an. Die Tradition des Krippenbaus zu erhalten und zu fördern, ist das Ziel der Krippenfreunde: Jeder Familie eine Krippe, lautet das Motto! Es gibt sogar einen weltweiten Verband, der 1957 in Barcelona gegründet wurde. Seit 6 Jahren leitet der Sekretär des Bischofs den Südtiroler Verein. Weihnachten bietet für religiöse Familien eine große Chance, weiß Horrer: „Wenn Eltern ihren Kindern an Weihnachten die Botschaft von der Geburt Jesu‘ erzählen, ist das wie Glaubensunterricht.“
Der Bau einer Krippe ist weit mehr als Figuren aufstellen. Es geht darum, die Evangelien nachzuerzählen. Weihnachtskrippen übersetzen die Botschaft der Engel in unsere Zeit: „Heute ist euch der Retter geboren!“ „Die Beschäftigung mit der Weihnachtsbotschaft ist die Beschäftigung mit Hoffnung. Diese Hoffnung und der Blick auf das Kind in der Krippe tun immer wieder aufs Neue gut“, ist Michael Horrer überzeugt. In der Weihnachtskrippe spiegelt sich für ihn die Weihnachtsbotschaft: „Gott ist Mensch geworden, ist verletzlich wie ein neugeborenes Kind, den Umständen ausgeliefert, ohnmächtig, wie auch wir es sind. In der Gestalt dieses Kindes möchte Gott unter den Menschen wohnen, ihnen nahe sein“.







Neapel gilt als das Mekka der Weihnachtskrippen. „Il presepe“ ist hier wichtiger als der Weihnachtsbaum und wird bereits am 8. Dezember aufgestellt. Das Jesuskind legen die Neapolitaner traditionell erst am Abend des 24. Dezembers dazu. Die Via San Gregorio Armeno, die im Volksmund auch „Via dei pastori“ genannt wird, ist weltweit als die „Straße der Krippenbauer“ bekannt. Dort gibt es neben Krippenfiguren auch alltägliche Nachbildungen wie Pizzabäcker oder Fischhändler, dazu alle möglichen Tierarten und sogar karikierte Politiker und Fußballspieler. Spannend sind die Entwicklungen und Varianten der europäischen Krippengeschichte, deren Blütezeit zwischen 1650 und 1850 lag. Italien und der südliche deutsche Sprachraum bilden einen besonderen Schwerpunkt. Eine europaweite Verbreitung fand die Weihnachtskrippe ab dem 16. Jahrhundert durch die Jesuiten. Im 19. Jahrhundert begannen die Grödner Bergbauern damit, während der Winterzeit Krippen aus Holz zu schnitzen. Sie fertigten die Heilige

Familie und ergänzten ihre Holzfiguren mit unzähligen Holztieren und Krippenställen. Auf diese Weise gelangten die Weihnachtskrippen nach und nach in viele Familien.

Krippenmuseen und Krippensammlungen

Von einer lebendigen Krippentradition in unserem Land erzählen das Krippenmuseum im Kloster Muri Gries in Bozen, das die Südtiroler Krippenfreunde aufgebaut und lange geleitet haben. Die Lofferer Krippe vom ehemaligen Loffererhof in Gries (um 1750 – Pfarrer P. Hilarius Imfeld erwarb die Krippe um das Jahr 1924) und die Prälatenkrippe von Augustin Alois Probst (1758 - 1807) sind Schmuckstücke der Krippenbaukunst. Ein Herzstück der Sarnser Krippenschule befindet sich im Vinzentinum bei Brixen. Es handelt sich um eine orientalische Krippe des Südtiroler Krippenpioniers Ferdinand Plattner. Eine riesige handgeschnitzte Krippe befindet sich in St. Christina. Bei dieser Weihnachtskrippe handelt es sich um ein Gemeinschaftsprojekt, bei dem insgesamt 18 einheimische Bildhauer mitgewirkt haben. Das Krippenmuseum „Maranatha“ in Luttach rühmt sich, die fantasievollste Krippenwelt Europas zu zeigen. Weitere Krippensammlungen gibt es im Ursulinenkloster in Bruneck, im Hotel Mondschein in Sexten, im

Die Krippensammlung in der Brixner Hofburg ist aber die bedeutendste überhaupt. Die ausgestellten Krippen aus zwei Jahrhunderten haben einen hohen künstlerischen Wert. Bis zu 5000 Figuren hat zum Beispiel die Krippe von Franz Xaver Nißl. Berühmt ist auch die sogenannte Lodron-Krippe. Zu sehen gibt es in Brixen Krippen aus Neapel, Sizilien, Papierkrippen, Guckkastenkrippen, Krippen aus Terrakotta, Wachs- und Elfenbeinkrippen, Fastenund Osterkrippen und sogar Jahreskrippen.
Krippen bauen lernen
„Der Startschuss fürs Krippenbauen ist bei vielen bereits in der Kindheit angelegt oder rund um die Familiengründung angesiedelt“, erzählt Horrer. Anliegen der Südtiroler Krippenfreunde ist es, den Krippenbau bei Kindern und Jugendlichen zu fördern. Helga Prünster, die Obfrau der Ortsgruppe Passeier-Riffian-Tirol, ist leidenschaftliche Krippenbauerin. In Riffian steht in der Passionszeit sogar eine Osterkrippe, die sie gebaut hat, im orientalischen Stil, nicht im heimatlichen. Wie der Name schon besagt, ist damit der Stil der
Darstellung gemeint, vor allem des Hintergrunds und der Figuren. Heimatliche Krippen sind in die Tiroler Landschaft eingebettet und zeigen die Ereignisse um Christi Geburt in szenisch aufgebauten Krippenlandschaften und passenden Figuren im heimatlichen Stil. Der Krippenbauer stellt die Geburt Jesu in seiner eigenen Lebenswelt dar, während bei der orientalischen Krippe die szenische Inszenierung nach Betlehem in den Orient versetzt wird. „Wir freuen uns, wenn Schulen das Krippenbauen fördern, und wir unterstützen sie dabei sehr gerne“, sagt Michael Horrer. Der Verein organisiert Krippenbaukurse, geplant ist auch die Eröffnung einer Schule für Krippenbaumeister.
Eine Krippe mit Ochs und Esel, mit Hirten und Schafen, mit Engeln und einem Stern, mit einem Stall, mit Josef und Maria und dem Jesuskind in der Mitte, diese Tradition geht auf den heiligen Franziskus zurück, der sie mit lebendigen Menschen und Tieren begründet hat. In der Christnacht des Jahres 1223 soll Franz von Assisi in einer Höhle bei Greccio eine Krippenfeier mit lebenden Tieren abgehalten haben. Für die Krippenfreunde weltweit wird das kommende Jahr daher zu einem besonderen Jubiläum: 800 Jahre Weihnachtskrippe!
 Museum „Heide“ in Pontives-Gröden und in St. Lorenzen in „Renatos Krippenhaus“.
Museum „Heide“ in Pontives-Gröden und in St. Lorenzen in „Renatos Krippenhaus“.
Ein halbes Jahrhundert später gab es die erste Krippe in den Kirchen Roms. Ochs und Esel kommen in der biblischen Weihnachtsgeschichte aber gar nicht vor. Dass sie dennoch zur Krippe gehören, hat damit zu tun, dass sie in den apokryphen Weihnachtsschriften sehr wohl genannt werden. Gemeint sind jene Texte, die nicht ins Neue Testament aufgenommen worden sind, aber recht folkloristisch das Leben Jesu erzählen. Und so heißt es dort, dass „am dritten Tage nach der Geburt unseres Herrn Jesus Christus“ ihr Kind in eine Krippe gelegt, „und Ochs und Esel beteten ihn an“ – also noch vor den „Heiligen Drei Königen“. Diese Überlieferung ist nicht nur folkloristisch; sie hat einen biblischen Hintergrund. Denn beim Propheten Jesaja heißt es: „Der Ochse kennt seinen Besitzer und der Esel die Krippe seines Herrn“ (Jes 1,3). Der Prophet will damit wohl

zeigen, wie schwer es für viele ist, zu verstehen, was in Bethlehem geschehen ist – und wie leicht für einen sturen Ochsen und einen dummen Esel, die einfach nur wissen, wohin sie gehören und wo sie etwas zum Fressen finden.


Nach Ostern ist Weihnachten das zweitgrößte Kirchenfest und das Kind in der Krippe spielt dabei die Hauptrolle. So heißt es in einer Predigt des Heiligen Hieronymus aus dem Jahr 385: „(…) Ich sehe mit Staunen, dass der Herr und Schöpfer der Welt nicht in Gold und Silber, sondern in Staub geboren wurde“. Auch für Michael Horrer ist das die Botschaft der Krippe. Die Hauptfigur ist das Jesuskind, ein Säugling, der in einem ärmlichen Stall in einer Futterkrippe liegt. Als „das Christuskind“ symbolisiert er

Gott, der ohne weltliche Besitztümer, in großer Armut zum Menschen geworden ist.


Pflegen wir die Krippenkultur

Franziskus wollte vor rund 800 Jahren die Frohe Botschaft den Menschen, die nicht lesen konnten, erfahrbar machen. Der Bau einer Krippe bedeutet, sich mit der Botschaft Jesu auseinanderzusetzen. Die Krippe erklärt Kindern, aber auch Erwachsenen, auf sinnlich-erfahrbar Weise diese Botschaft. Nutzen wir deshalb Weihnachten, um den größten Schatz Europas lebendig zu halten: das Wissen um Jesus Christus, den Erlöser, dessen Geburt an Weihnachten gefeiert wird. Vielleicht haben auch Sie eine Krippe irgendwo verstaut und ganz vergessen? Es ist jetzt Zeit, sie herauszuholen…

Wer mit dem Rad von Algund kommt und Richtung Marling fährt, der erreicht über die Nörderstraße teils entlang des Bahndamms nach einigen Kilometern und am Oberwirt vorbei die Franz-Innerhofer-Straße. Der 36-jährige Schulleiter und Kapellmeister, nach dem die Straße benannt ist, wurde am 24. April 1921 während eines Trachtenumzugs im Rahmen der Bozner Frühjahrsmesse von faschistischen Schlägertrupps erschossen. Dabei forderte er lediglich den Trachtenhut zurück, der einem seiner Schüler von faschis-
tischen Schwarzhemden gestohlen worden war. Einer von denen zog daraufhin einen Revolver und schoss Innerhofer in die Brust. Er überlebte nur wenige Minuten. 48 weitere Personen wurden damals verletzt – es war der Bozner Blutsonntag, von dem wahrscheinlich schon jeder einmal in der Schule gehört hat. Radelt man auf dieser Straße weiter, so entdeckt man zur rechten Hand am Tiroler Platzl hinter der Bushaltestelle ein beeindruckendes Monument, das aus vier großen, hinkelsteinförmigen Felselementen besteht.
Wie in Tirol seit 1909 üblich, wird alle 25 Jahre der Ereignisse von 1809 rund um Andreas Hofer und den Widerstand gegen Bayern, Sachsen und Franzosen gedacht. Das letzte Mal also vor dreizehn Jahren 2009. Zu diesem 200. Gedenkjahr erschienen eine ganze Reihe neuer Bücher und Studien über den Tiroler Oberkommandanten und seine wechselvolle Zeit. Das Museum in St. Leonhard wurde großzügig ausgebaut, ein Andreas-Hofer-Bus tourte über ein Jahr lang durch das Land, so gut wie jede Heimatbühne hatte ein Hofer-Stück im Programm und der Sandwirt startete eine Zweitkarriere als Comic-Held in der erfolgreichen Publikation von Jochen Gasser und Norbert Parschalk.


Auch Marling hatte sich etwas Besonderes einfallen lassen. Auf Initiative des Freundschaftskreises Marling-Kals am Großglockner und der Gemeindeverwaltung des Ortes wurde die Parkinsel an der Franz-Innerhofer-Straße neu gestaltet. Vier Findlinge aus den vier Landesteilen wurden nebeneinander aufgestellt und mit den jeweiligen Wappen versehen, ebenso mit der Flächenangabe, dem höchsten Berg, dem Hauptort und
der damals aktuellen Einwohnerzahl. Die naturbelassene Gestaltung repräsentiere Zeitlosigkeit und ermögliche auch zukünftigen Generationen, ihr Wertschätzung entgegenzubringen. Für Nordtirol steht der Kramsacher Marmor aus dem gleichnamigen Ort, für Osttirol ein Serpentinit Tauern Grün aus der mit Marling befreundeten Gemeinde Kals, für Südtirol ein Granit Rieserferner Tonalit aus dem Reintal und für Welschtirol ein Porphyr Camparta Rosso oro aus dem Cembratal.

Der feste Sockel, auf dem die vier Felsen ruhen, solle Gesamttirol darstellen, das auf einer davor liegenden Steinplatte abgebildet ist. Für Entwurf, Planung und ausführende Arbeiten zeichnete Steinmetz Andreas Tscholl aus Schenna-Naif verantwortlich. Feierlich eingeweiht wurde das Tiroler Platzl mit den Gedenksteinen am 25. Oktober 2009 unter Landeshauptmann Luis Durnwalder und Bürgermeister Walter Mairhofer. Der damalige Vizepräsident des Regionalrates Seppl Lamprecht betonte bei der Feier: „Was hier geschaffen wurde, ist etwas Bleibendes. Die vier Felsen bilden eine Einheit, wenn das Land auch zerrissen wurde.“
Christian Zelger























































































Glaube nicht alles, was dir vom schillernden, weltoffenen Katar vorgegaukelt wird. Im Internet findest du verschiedene vertrauenswürdige Quellen, die die Zustände in Katar genauer beleuchten. Und wenn du keine Lust zu lesen hast, findest du auch viele Videos zu diesem Thema.





Frauenrechte in Katar. Frauen haben wenig bis keine Rechte, sie werden unterdrückt und dürfen weder Sachen alleine machen, anziehen was sie wollen oder Sport machen. Junge Frauen müssen, wenn sie reisen, heiraten oder studieren wollen erst die Erlaubnis ihres männlichen Vormundes einholen. Die Vormundschaft und die Entscheidungsrechte des Mannes werden teilweise als gottgegeben und somit unantastbar angesehen. Wird in Katar beispielsweise eine Frau vergewaltigt, kann es sein, dass sie danach auch noch eingesperrt wird, weil sie Sex außerhalb der Ehe hatte.
Die Verlierer bei der WM in Katar sind, ganz klar, die Menschenrechte! Und wer sind die Gewinner? Wie so oft nur einige wenige. Und dabei sollte es ja um Fußball gehen - um den allseits beliebten Sport, der Millionen von Menschen fasziniert und zusammenführt, der für Spaß, Mitfiebern, Spannung und Unterhaltung steht. Aber ist das bei dieser WM möglich? Kann man die Lügen, Korruption und Ausbeutung einfach ausblenden um des Sportes willen? Ist es egal, dass Homosexuelle bestraft werden oder, dass Frauen so gut wie keine Rechte haben? Kann man darüber hinwegsehen, dass Häuser niedergebrannt wurden, um ein Fußballstadion zu bauen oder, dass Väter und Mütter als Gastarbeiter umgekommen sind, weil in Katar für ärmere Menschen fast noch Sklaverei ähnliche Arbeitsverhältnisse herrschen? Schwierig, oder!?
Wieviel sind uns die eigenen Werte wert? Aus diesen und ähnlichen Gründen haben viele Menschen beschlossen, die Fußball-WM heuer nicht zu verfolgen. Fußball-Fanclubs haben sich der Kampagne „Boycott Qatar“ angeschlossen und verzichten bewusst auf ihren geliebten Fußball. Musiker haben Auftritte bei der WM abgelehnt, obwohl sie dafür eine Gage in Millionenhöhe erhalten hätten. Das sind nur einige der offenen oder stillen Proteste, die derzeit vonstattengehen. All dies in der Hoffnung, dass es nicht mehr möglich sein wird, Sportevents wie die WM in Ländern auszutragen, welche die Menschenrechte so offensichtlich mit Füßen treten. Denn unser Vergnügen darf nicht mehr wert sein als unsere Werte!
Jugenddienst

Hast du keine Ahnung, was du in den Weihnachtsferien machen könntest?
Lust aufs Rodeln, Eislaufen oder hast du eine coole Idee, was wir zusammen machen könnten? Melde dich bei uns oder folge uns auf
Instagram, facebook oder schau auf unsere Homepage, um über die aktuellen Aktionen in den Ferien informiert zu sein!
…auch unsere Jugendtreffs haben spezielle Christmas-Holiday Öffnungszeiten für dich!!



Das Angebot gilt nur bei Abschluss in der Anzeigenabteilung Bozen oder in einer unserer Hauptfilialen Brixen, Bruneck, Meran, Schlanders, Sterzing und nur bis zum 06.01.2023. Das Angebot ist gültig nur für Neuabonnements mit Wohnsitz im Inland (keine Abbestellung/Umbestellung im selben Haushalt in den letzten 6 Monaten).

Bleibe nicht am Boden heften, Frisch gewagt und frisch hinaus! Kopf und Arm mit heitern Kräften, Überall sind sie zu Haus; Wo wir uns der Sonne freuen, Sind wir jede Sorge los. Daß wir uns in ihr zerstreuen, Darum ist die Welt so groß.

Die Anzahl der gewonnenen WM-Titel sagt verhältnismäßig wenig über den aktuellen Leistungsstand einer Nationalmannschaft aus.
Bei der Fußball-Weltmeisterschaft im Jahr 2018 gewann Frankreich das Turnier. Im Finale setzten sich die Franzosen mit 4:2 gegen Kroatien durch. Im Jahr 2014 gewann Deutschland die Weltmeisterschaft, Gastgeberland war damals Brasilien. Auf der FIFA Weltrangliste belegen Brasilien, Belgien und Argentinien zurzeit die drei Spitzenplätze und sind somit die Favoriten der WM. Bei der Fußball-Weltmeisterschaft 2018 in Russland wurden insgesamt 169 Tore geschossen und damit zwei weniger als vier Jahre zuvor in Brasilien. Brasilien, Belgien, Argentinien bilden die Spitze der FIFA Fußball-Weltrangliste der Fußballnationalmannschaften der Männer. Der Hersteller Adidas rüstet bei der heurigen WM insgesamt sieben Teams aus, darunter Deutschland. Der Ausrüster der meisten WM-Teams ist jedoch Nike mit 13 Nationalmannschaften. Den höchsten gesamten Marktwert der Teilnehmer hat England mit mehr als 1,2 Milliarden Euro. Den geringsten Marktwert weist u.a. Costa Rica mit rund

19 Millionen Euro aus. 2022 hatten die englischen Nationalspieler Harry Kane und Phil Foden jeweils einen Marktwert von 90 Millionen Euro. Damit gehören sie zu den wertvollsten Fußballern der gesamten Weltmeisterschaft. Der teuerste Spieler ist der Franzose Kylian Mbappe mit einem Wert von 160 Millionen Euro. Noch nie war das Preisgeld bei einer WM so hoch wie diesmal. Jeder
Allen Lesern DANKE!


Danke für Euer Vertrauen. Danke, dass wir uns um Eure Autos kümmern durften. Wir wünschen allen ein frohes Fest!

Spieler der Siegermannschaft erhält eine Prämie von 400.000 Euro. Der deutsche Nationaltrainer Hansi Flick bekommt laut Quelle ein Jahresgehalt von rund 6,5 Millionen Euro und ist damit der bestverdienende Trainer der Fußball-WM 2022 in Katar. Das geringste Gehalt erhält Tunesiens Nationaltrainer Jalel Kadri mit geschätzten 130.000 Euro. Auto Erb, Max-Valier-Straße 6-8, 39012 Meran (BZ), Tel 0473 233 100, info@auto-erb.it, www.autoerb.mercedes-benz.it



Seit Ende November können Familien mit dem EuregioFamilyPass Preisnachlässe beim Ausleihen von Wintersportausrüstung, beim Eintritt in Eislaufplätze oder bei Hockeyspielen beanspruchen.
Nach der beliebten Schwimmbadaktion im Sommer gibt es heuer erstmals auch eine Winteraktion des EuregioFamilyPass Südtirol. Dabei gibt es für alle, die im Besitz eines gültigen EuregioFamilyPass Südtirol sind, eine 50-prozentige Ermäßigung bei allen Partnerbetrieben der Winterfamilienerlebnisaktion.
Der Rabatt gilt auch für Inhaber des EuregioFamilyPass aus Tirol und dem Trentino. Der Rabatt kommt beim Ausleihen von Wintersportausrüstung, beim Eintrittspreis in Eislaufplätzen oder beim Eintritt zu ausgewählten Heimspielen mehrerer Südtiroler Hockeymannschaften zur Geltung.
Der EuregioFamilyPass Südtirol ist die Vorteilskarte für Südtiroler Familien mit minderjährigen Kindern. Rund 18.000 Karteninhaber nutzen bereits die Vorteile und Preisnachläs-
se, die unter anderem in der öffentlichen Mobilität, in Geschäften oder Freizeiteinrichtungen gewährt werden. „Seit seiner Einführung im Jahr 2017 hat der EuregioFamilyPass Südtirol dazu beigetragen, dass Familien in ganz Südtirol kleinere und größere Preisnachlässe in Anspruch nehmen können. Mit der Winteraktion wollen wir in den kommenden
Wochen und Monaten Anreize für tolle, gemeinsame Winterfamilienmomente schaffen“, betont Familienlandesrätin Waltraud Deeg.
Alle Informationen zur Aktion, die von Ende November bis Ende Februar läuft, unter www.provinz.bz.it/familypass.
Wir schaffen Lebensräume für morgen.


Rätsel: Wie viele Strophen hat „Stille Nacht“ in der Originalfassung?
o 4 o 5 o 6

Schreib die Antwort auf eine Karte und schick sie uns mit Angabe deines Alters bis Monatsende an: „Die BAZ“, Industriestr. 1/5, 39011 Lana oder per E-Mail an info@vereinkinderwelt.com
Die Gewinnerin der Oktober-BAZ heißt Sofia Lampacher, 5 Jahre Der Gewinn wird zur Verfügung gestellt von der Buchhandlung Athesia, Meran.
Wichtelweihnacht im Winterwald
Autor: Ulf Stark
Verlag: Friedrich Oetinger GmbH
ISBN: 13: 978-3789147500 Alter: ab 4 Jahren

Material: kleine Zapfen, Holzkugel, ø 2,5 cm, Holzperle, ø 6 mm, Bastelfilz in Weiß, 18 cm x 12 cm, Glöckchen in Silber, ø 8 mm, Filzstift in Schwarz, Nähgarn in Weiß, Nähnadel, Cutter, Schere, Heißkleber evtl.
Birkenrinde zum Verzieren* Anleitung: Klebt die Holzkugel mit Heißkleber am Zapfen fest. Spaltet die kleine Holzperle mit einem Cutter. Klebt dann eine Perlenhälfte als Nase mittig auf die Holzkugel. Malt dann mit schwarzem Filzstift zwei kleine Punkte als Augen auf. Für die Mütze schneidet ihr einen Viertel Kreis aus dem Filz und klebt die Außenkanten übereinander, sodass eine Zipfelmütze entsteht. Befestigt dann am Zipfel mit Garn und Nadel das Glöckchen. Schneidet für den Schal aus dem Filz einen circa 2 cm breiten und 15 cm langen Streifen zu und schneidet die Enden mit einer Schere etwa 1,5 cm tief ein, sodass kleine Fransen entstehen. Klebt die Mütze mit Heißkleber auf dem Kopf des Wichtels und wickelt den Schal um den Hals herum. Zum Aufhängen des Wichtels einen doppelten Faden um das Glöckchen herumbinden und an den Enden verknoten. Den Wichtel zusätzlich noch mit Sternen aus Birkenrinde schmücken, wie im Foto!
Text und Foto: https://www.geo.de/geolino/basteln/19953-rtkl-basteln-putzige-wichtelanhaenger

Wie kommen Eiszeiten zustande?
Als Eiszeit (Glazial) bezeichnet man eine über mehrere Jahrhunderte oder Jahrtausende anhaltende Phase in der Erdgeschichte, in der es deutlich kühler ist und es zu einer enormen Ausbreitung von Gletschern in den Gebirgen und der polaren Eisschilde kommt. Eine der Hauptursachen für die zyklisch auftretenden Eis- und Warmzeiten sind Veränderungen der Erdbahngeometrie. Diese wird durch wechselseitige Gravitationskräfte im System Sonne, Erde, Mond beeinflusst. Die Form der elliptischen Erdumlaufbahn um die Sonne (Exzentrizität) ändert sich mit einer Periode von etwa 100.000 Jahren, die Neigung der Erdachse zur Umlaufbahn (Ekliptik) mit einer Periode von etwa 40.000 Jahren, während die TagNacht-Gleiche auf der elliptischen Umlaufbahn etwa nach 20.000 Jahren wieder dieselbe Position auf der Ellipse einnimmt (Präzession). Durch diese Zyklen verändert sich die Verteilung der Sonnenenergie auf der Erde. Die Vermutung der Wissenschaftler: Eine Eiszeit tritt immer dann auf, wenn die Sommersonnen-Einstrahlung in hohen nördlichen Breiten minimal wird. Kühle Sommer sind danach für den Eisaufbau entscheidender als kalte Winter.
Text und Foto: https://www.planet-wissen.de/natur/klima/eiszeit/index. html


Wir wünschen euch einen schönen Advent, frohe Festtage und einen guten Rutsch ins Neue Jahr. Im Jänner stellen wir euch das Sommerprogramm 2023 vor! Seid gespannt.
Fröhliche Weihnachten, euer Verein Die Kinderwelt Team




Alle Infos direkt im Büro: „Die Kinderwelt Onlus“ Boznerstraße 78 39011 Lana Tel. 0473 211634 info@vereinkinderwelt.com www.vereinkinderwelt.com
 In Zusammenarbeit mit dem Verein „Die Kinderwelt Onlus“
In Zusammenarbeit mit dem Verein „Die Kinderwelt Onlus“

Die Zeit vor Weihnachten ist politisch ganz der Erstellung des Haushaltes für das darauffolgende Jahr gewidmet. Es ist das wichtigste politische Statement einer Regierungsmehrheit.

Das erste Haushaltsgesetz der Regierung Meloni enthält wenig Licht und viel Schatten. Der Entwurf, den der Ministerrat verabschiedet hat, wird nun Gegenstand der parlamentarischen Beratungen sein. Positiv ist, dass er einen großen Teil der Maßnahmen der Regierung Draghi gegen die hohen Energiekosten beibehält. Doch hier hören die guten Nachrichten schon fast auf.
Weniger positiv ist, dass mit diesem Haushalt eine Umverteilung von unten nach oben erfolgt. Die Streichung des sogenannten Bürgereinkommens für rund 600.000 Menschen ab September 2023, die Kürzung der Gelder für die von der Draghi-Regierung vorgesehene Rentenanpassungen ab dem Jahr 2023, die unzureichenden Mittel für die öffentliche Gesundheitsversorgung, sind Belege dafür. Aber auch die Senkung der Lohnnebenkosten ist viel zu zaghaft und die steuerliche Erleichterung der Boni für Beamte konzentriert sich auf höhere Einkommen. Die Umsatzschwelle, ab der Selbstständige mit 15 % pauschal besteuert werden, wird auf 85.000 Euro angehoben, was zu einer erheblichen Diskrepanz zu Arbeitnehmern mit gleichem Einkommen führt, die einer viel ungünstigeren Steuerre-
gelung unterliegen. Das Haushaltsgesetz enthält außerdem die Botschaft, dass der Bekämpfung der Steuerhinterziehung keine Priorität eingeräumt wird. Die Grenze der Barzahlungen wird auf 5000 Euro angehoben und die Strafe für Händler, die keine elektronischen Zahlungen akzeptieren, greift erst ab 60 Euro. Dies obwohl 80 % aller bargeldlosen Transaktionen Beträge von unter 60 Euro zum Gegenstand haben. Vor allem werden alle Steuerbescheide unter 1000 Euro bis zum Jahr 2015 vernichtet, womit es sich für viele ausgezahlt hat, die Steuern nicht zu bezahlen. Die Dummen sind diejenigen, die sie gezahlt haben. Es ist bekannt, dass von den 41 Millionen potenziellen Steuerzahlern 5 Millionen 60 % der Einkommensteuer schultern. Daher müsste die Bekämpfung der Steuerhinterziehung zu den größten Prioritäten der italienischen Regierung gehören.
Dies haben sowohl Staatspräsident Mattarella als auch die Europäische Union im Zusammenhang mit dem Haushalt angemahnt. Daraufhin hat Ministerpräsidentin Meloni angekündigt, dass zumindest die Grenze von 60 Euro, über welcher den Kunden das Zahlen mit Karte garantiert werden muss, überdacht
wird. Wenig Licht und viel Schatten auch bei Frauen und Gleichstellung. Positiv ist, dass die Mehrwertsteuer auf Menstruationsprodukte endlich von 10 % auf 5 % gesenkt wird. Leider fehlen im Entwurf jedoch die von Präsidentin Meloni versprochenen Maßnahmen zur Förderung der Erwerbstätigkeit von Frauen völlig. Dafür findet sich eine Neuerung, die in die entgegengesetzte Richtung geht: es wird ein zusätzlicher Monat Elternurlaub mit einer Vergütung von 80 % eingeführt. Dieser allerdings nur für Frauen! Damit wird die Aufgabenteilung zementiert, wonach die gesamte unbezahlte Familienarbeit auf den Schultern von Frauen lastet. Kein zeitgemäßer politischer
Unterberger SenatorinAnsatz. Jedenfalls bleibt zu hoffen, dass das Haushaltsgesetz im Parlament noch verbessert wird!


100 Jahre alt ist die Idee, aus der mit Dr. Schär der Weltmarktführer für glutenfreie Ernährung entstanden ist. Es ist ein Familienunternehmen, das tief in Südtirol verwurzelt ist und von dort den Weg in die Welt gefunden hat – mit mittlerweile 18 Standorten in elf Ländern. Als Südtiroler Unternehmen spielen die heimischen Produktionsstandorte in Burgstall und Leifers eine besondere Rolle. „Sie bilden mit dem Hauptquartier in Burgstall das Rückgrat unseres Unternehmens und wachsen stetig“, erklärt CEO Philipp Schoeller.
Die Herausforderung, die damit verbunden ist, ist die Suche nach neuen Mitarbeitern, die dieses stetige Wachstum auch langfristig sichern. „Wir wissen ganz genau, dass unser Erfolg auf Qualität, Nähe, Innovation und Nachhaltigkeit fußt und all das nur gewährleistet werden kann, weil sich unsere Mitarbeiter ins Zeug legen – auch und vor allem die 180 Beschäftigten, die 24/7 unsere Produktion in Südtirol vorantreiben“, so Schoeller.
Die Wertschätzung, die man den Mitarbeitern entgegen bringt, geht weit über lobende Worte hinaus. „Mitarbeiter, egal ob bewährte oder
neue, haben am Erfolg unseres Unternehmens teil“, so der CEO. So gibt es bei Dr. Schär nicht „nur“ 14 Gehälter, sondern für alle, die in der Produktion auch Sonntagsdienst leisten, ein zusätzliches 15. Gehalt. Darüber hinaus können in der Herstellung beschäftigte Pendler mit einer Fahrtkostenzulage rechnen und Ende des Jahres winkt eine Produktionsprämie in Höhe eines Monatsgehalts. „Im Dezember gibt’s also gleich drei Gehälter“, erklärt Herbert Spechtenhauser, Personalchef bei Dr. Schär. Und weil das Leben schon teuer genug ist, unterstützt Dr. Schär seine Mitarbeiter mit gezielten Förderungen. Die Palette reicht von der kostenlosen Mensa für Mitarbeiter in der Produktion über eine Zusatzkrankenversicherung bis zur betriebseigenen Kita. Schon die monetären Anreize für die Mitarbeiter sind bei Dr. Schär also hochinteressant. Darüber hinaus wird das Personal auch anderweitig unterstützt und gefördert. So arbeitet man konstant daran, das gute Arbeitsklima beizubehalten, experimentiert mit neuen Arbeitszeit-Modellen, lässt eine flexible Dienstplanung zu und investiert in die Ent-

wicklung des Personals. Die Dr. Schär-Academy bietet ein umfassendes Weiterbildungsangebot und öffnet dadurch auch Karrierewege im Unternehmen. „Es zeigt sich an vielen Beispielen, wie weit Mitarbeiter, die über Jahre bei uns bleiben, die Karriereleiter nach oben steigen“, so Spechtenhauser.
Die wichtigsten Informationen darüber gibt’s unter www.drschaer.com/de/karriere



Ein Todesfall bringt viele Herausforderungen mit sich. Hilfe in dieser schwierigen Zeit finden Betroffene unter trauer.bz – Die ersten Schritte nach einem Todesfall, Dienstleister, Textvorlagen für Beileidsbekundungen und passende Worte für den Trauerfall.


Die „grüne“ Industriezone Lana und das Naherholungsgebiet „Falschauer“ bilden in Lana das sogenannte „Falschauer Delta“. Der Standort ist gekennzeichnet von einem rührigen Gewerbe, einer großzügigen Sportanlage, der „Lanarena“ und einem idyllischen Naherholungsgebiet für Familien und Naturliebhaber. Die BAZ sprach mit Bürgermeister Harald Stauder.
von Philipp GenettiWas macht die Industriezone Lana als Wirtschaftsstandort attraktiv?
Harald Stauder: Die Attraktivität ergibt sich aus unterschiedlichen Aspekten. Einerseits ist die verkehrstechnische Lage ideal, direkt an der Ausfahrt von der Schnellstraße Meran Bozen. Andererseits waren wir in der Lage allen Unternehmen, bei Notwendigkeit eine Erweiterungsmöglichkeiten zu bieten. Die Ansiedlung von Unternehmen, die auch auf dem globalen
Markt anzutreffen sind und dort erfolgreich sind, zeigt uns, dass einiges richtig gemacht wurde.
Welche Vorteile haben Unternehmen hier?
Das Angebot außerhalb der eigentlichen Produktion ist in den vergangenen Jahren gewachsen. Die Industriezone verfügt heute über mehrere Gastronomiebetriebe, über eine Kindertagesstätte sowie unmittelbar angrenzend über Sportanlagen. Rund 5 Minu-
ten zu Fuß entfernt finden wir das Naherholungsgebiet Falschauer mit einem Biotop, das nicht nur in der Mittagspause von vielen gern aufgesucht wird.
Die Industriezone ist auch bekannt als „grüne Industriezone“. Was bedeutet das? Grüne Industriezone deshalb, weil der ehemalige Wirtschaftsreferent der Gemeinde, Roland Gruber bei der Umgestaltung der Freiflächen Wert daraufgelegt hat,
dass möglichst viele Bäume, Sträucher und Blumen gepflanzt werden. Diese Idee bewährt sich heute in vielfacher Hinsicht, vom ästhetischen Gesichtspunkt und für die Kühlung im Sommer.
Inwieweit spielt Nachhaltigkeit in der Zone eine Rolle?
Nachhaltigkeit ist für die Unternehmen mittlerweile Pflicht. Viele Kunden legen Wert darauf, für viele Verbraucher ist sie mit ein Kaufargument. Und natürlich ist
auch der finanzielle Aspekt zu berücksichtigen, nachhaltig heißt zum Teil auch sparsamer Umgang mit Energie und Ressourcen.

Hier haben sich neben regionalen auch internationale Betriebe angesiedelt. Was macht den Branchenmix aus?
Der Branchenmix ist historisch gewachsen. Erfolgreiche Betriebe sind gewachsen und haben den Standort noch bekannter gemacht; andere sind dazugekommen. Die Innovationskraft hat sich durch die Vielfalt einmal mehr weiterentwickelt. Der Kleine profitiert vom Großen und umgekehrt.
Trotz seines teils internationalen Charakters bietet die Zone vor allem Arbeitsplätze für einheimische Fachkräfte.
In der Industriezone arbeiten vor allem Mitarbeiter, die aus einem Umkreis von zirka 30 km einpendeln. Arbeitern aus Lana und Umgebung eine Arbeitsstelle zu geben, war die ursprüngliche Idee bei der Schaffung des Gewerbegebietes. Das ist bis heute so geblieben. Es ist eine Win-Win-Situation. Betriebe können auf bewährte Arbeitskräfte zählen und Arbeitssuchende finden einen zukunftssicheren Arbeitsplatz in der Nähe.
Die Entscheidungshoheit über die Gestaltung der „Industriezone von Landesinteresse“ teilen sich die Gemeinde Lana und das Land Südtirol gemeinsam. Was hat das konkret zu bedeuten? Dass wir grundlegende strategische Entscheidungen mit der Landesverwaltung absprechen.

Welche Herausforderungen stellen sich aktuell in der Zone? Inwiefern besteht noch die Möglichkeit der Erweiterung? Nachdem wir in den vergangenen Jahren die Infrastrukturen in der Industriezone erneuert und die Oberflächengestaltung abgeschlossen haben, stehen derzeit keine großen Maßnahmen mehr an. Auch Erweiterungen sind derzeit nicht möglich, da keine Grundverfügbarkeit gegeben ist. Wir grenzen mit der Zone an das Gemeindegebiet von Tscherms. Die Entscheidung über Erweiterungen in Richtung Norden liegt also nicht bei uns. Langfristig kann in enger Abstimmung mit der Landesverwaltung an die Sanierung des ehemaligen Müllhügels an der Einfahrt zur Zone gedacht werden. Die Zeit dafür ist dafür jedoch noch nicht reif.
Mit der Sportzone „Lanarena“ befindet sich ein Standort für den Sport in der Industriezone. Wie ist es dazu gekommen?
Die „Lanarena“ steht dort, wo bereits früher Tennisplätze und ein Fußballplatz waren. Sie entstand Anfang der 2000er Jahre und beherbergt heute eine Tennishalle, verschiedene Sporthallen und ein Restaurant.
Welchen Stellenwert hat diese Sportzone für Lana? Aus heutiger Sicht würde man so eine Sportanlage näher an die Ortsmitte bauen und nicht direkt an eine vielbefahrene Anfahrtsstraße. Erreichbarkeit von Sportund Freizeiteinrichtungen mit dem Fahrrad oder sogar zu Fuß, ist ein wichtiges Thema für uns. Die Anlage funktioniert heute sehr gut, da der Betreiber in der Lage war, sein Wissen rund um den Tennissport mit der Gastronomie zusammenzuführen.
Mit dem Verlauf der neuen Buslinie „LanaBus“ wurde auch die nahgelegene Naherholungszone „Falschauer“ aufgewertet. Welche Gedanken verfolgt die Ge-
meinde in Hinblick auf dieses Gebiet?



Das Naherholungsgebiet Falschauer wird auch in den nächsten Jahren sehr sanft weiterentwickelt werden. Der Spielplatz wird im Frühjahr in einem Projekt mit der Forstverwaltung erneuert, wodurch die Grillstellen etwas weniger werden. Jedoch bleiben die Freiflächen weiterhin großzügig. Naturnahes Spielen für Kinder steht im Vordergrund. Die Zeiten, in denen jedes Wochenende Duzende von Autos die Naherholungszone zugeparkt haben, überall gegrillt und alles verdreckt und vermüllt hinterlassen wurde, sind vorbei. Gemeinsam mit dem Fischereiverein haben wir eine Lösung gefunden, nachdem das Land nichts unternommen hat.
Etwas versteckt führt ein schmaler Spazierweg zu einem idyllischen Weiher. Weshalb wird dieses kleine Stück Paradies nicht intensiver genutzt?
Das Biotop steht für Artenvielfalt und geschützten Lebensraum. Das wird auch so bleiben. Es soll eine Oase der Ruhe bleiben, für Menschen, die das zu schätzen wissen. Die Landesverwaltung hat auf unsere mehrmalige Anfrage nach einem „Biotopwächter“ nie reagiert. In anderen Regionen gibt es sogenannte „Guardie ambientali“, die solche Aufgaben übernehmen. Wir versuchen jetzt über die Ortspolizei und den Lananer Fischereiverein Ordnung zu halten.
Was wünschen Sie sich für die Zukunft für die Naherholungszone „Falschauer“?
Die Naherholung entlang der gesamten Falschauer, von der Gaulschlucht bis zur Mündung in die Etsch, wird weiterhin so gestaltet, dass sie familiengerecht ist und die Menschen in unmittelbarer Nähe ihrer Wohnung Natur erleben können. Darauf haben wir hingearbeitet, so soll es auch bleiben.
Vor 70 Jahren begann die Geschichte von HOPPE mit einem kleinen Fertigungsbetrieb in der Nähe von Düsseldorf. Heute ist aus der kleinen Lohnschleiferei eine international tätige Unternehmensgruppe geworden: Mit Standorten rund um den Globus – einer davon im Eurocenter in Lana.
In Südtirol ist HOPPE mit über 750 Mitarbeitern der größte Arbeitgeber der Region. Anlässlich des 70-jährigen Bestehens des Unternehmens blicken wir zurück auf die Entwicklung zum führenden Beschlaghersteller in Europa.
Am 5. November 1952 gründete Friedrich Hoppe in Heiligenhaus bei Düsseldorf ein Unternehmen zur Herstellung von Türbeschlägen. 1954 verlagerte er sein Unternehmen nach Stadtallendorf bei Marburg – fernab der Konkurrenz – und stellte damit die Weichen für stetiges Wachstum. Schon zwei

Jahre später folgte das erste Zweigwerk im 50 Kilometer entfernten Bromskirchen, das sich auf eine Großserien-Fertigung der Fenstergriffe und Türbeschläge konzentrieren sollte.
In den frühen 1960er Jahren waren die Kapazitäten der beiden Standorte ausgeschöpft und Friedrich Hoppe machte sich auf die Suche nach einem weiteren Produktionsstandort. Getreu seiner Philosophie, die Arbeit zu den Menschen zu bringen, wagte er den Schritt über die Grenzen nach Schluderns in Südtirol, wo 1964 ein neues Werk entstand. 1971 wurde in Müstair (Schweiz) ein weiterer Standort aufgebaut. Heute befindet sich dort der Hauptsitz der HOPPE-Gruppe.
Ab den 1970er Jahren expandierte und internationalisierte sich das Unternehmen weiter: Repräsentanzen und Tochtergesellschaften wurden eröffnet, weitere neue Werke entstanden in Südtirol, Deutschland, Tschechien und Nordamerika. Nach der Wiedervereinigung Deutschlands wurde in Crottendorf (Erzgebirge) ein ehemaliger Volkseigener Betrieb übernommen, zusätzlich investierte man dort in den Bau einer neuen Produktionsstätte. Auch neue Werkstoffe kamen im Laufe der Jahre zu Aluminium hinzu: 1975 begann die Verarbeitung von Messing, 1987 erweiterte HOPPE sein Sortiment um Kunststoff-Beschläge, die fortan im neu errichteten Werk in Laas gefertigt wurden, ab 1995 werden
Beschläge aus Edelstahl hergestellt.
1992 legte der Pionierunternehmer Friedrich Hoppe die Führung der HOPPE-Gruppe offiziell in die Hände seiner beiden Söhne Wolf und Christoph Hoppe. Mit dem Eintritt von Christian Hoppe in das Unternehmen ist der erste Vertreter der dritten Generation aktiv.
2014 zog die Verwaltung der italienischen Tochtergesellschaft in das Eurocenter in Lana. Die Gesellschaft heißt seitdem HOPPE AG, Lana. Von dort lassen sich sowohl die beiden Werke in Laas und Schluderns, wie auch Meran und Bozen gut erreichen.
Was 1952 in Heiligenstadt begonnen hat, ist heute zu einem weltweit tätigen Unternehmen mit 23 Standorten auf drei Kontinenten und rund 2900 Mitarbeitern geworden. HOPPE hat sich – wie auch seine Produkte – ständig weiterentwickelt. Mittlerweile bietet die HOPPE-Gruppe mit den beiden Marken „HOPPE – Der gute Griff.“ und „ARRONE – The complete range.“ ein Produktportfolio, das auf die Bedürfnisse der internationalen Märkte abgestimmt ist. Auch das Angebot an innovativen eTürbeschlägen und eFenstergriffen wächst kontinuierlich und bietet sowohl komfortable, schlüssellose Zutrittsmöglichkeiten für die Haustür, wie auch Komfort-, Schutz- und Energiespar-Komponenten für Smart Home.

Industriezone 1/5 - Eurocenter 39011 Lana (BZ)
Telefon: 0473 640 111
E-Mail: info.it@hoppe.com
Web-Site: www.hoppe.com
Der Unternehmensgründer Friedrich Hoppe v. l.: Die Unternehmer Christoph, Wolf und Christian Hoppe„Wir laufen immer wieder Gefahr, die Tatsache des Klimawandels zu verdrängen“, meinte Bürgermeister Erich Ratschiller in seinen Grußworten. Der vergangene Sommer habe uns spüren lassen, wie unmittelbar Klimakatastrophen auch unsere Breiten treffen können wiedas „Hochwasser in Ahrntal“ und das „Unglück auf der Marmolata“. Umso wichtiger sei es, sich mit den Zahlen und Fakten der Klimaforschung bekannt zu machen, um –wo immer noch Handlungsfenster offen seien – den Klimawandel bestmöglich zu verlangsamen. Dabei sind aber alle gefordert, so Ratschiller, die Bürger wie die Gemeinde. In Zusammenarbeit mit dem Land Südtirol sei man als Verwaltung schon dabei, das Nachhaltigkeitskonzept der UNO und die darin beinhalteten 17 Themen umzusetzen. Vor dem Hintergrund der ansteigenden Energiekosten sieht der Bürgermeister die Chance klimabewusster zu leben. Nach den Grußworten der Vorsitzenden des Tiroler Bildungsausschusses Elisabeth Pircher, zeigte der Univ. Professor für Klima- und Kryosphärenwissenschaften Dr. Georg Kaser den aktuellen Wissensstand zum Klimawandel (Stand: April 2022). Eines stehe laut Georg Kaser außer Frage: „Die Anzahl atmosphärischer Extremereignisse mehren

sich!“ Am Beispiel Pakistans hätte man sehen können, wie rasant sich globale Wetterverhältnisse verändern können. Nach einer extremen Trockenperiode folgte dortzulande ein außergewöhnlich heftiger und lange andauernder Monsunregen, der rund 33 Millionen Menschen wenigstens vorübergehend die Lebensgrundlage entzogen hatte. Auch der mittlere jährliche Meeresspiegelanstieg von derzeit 4,4 mm beunruhigt Kaser. Mit immer wahrscheinlicher werdenden Rückkoppelungsprozessen in der Antarktis und in Grönland sei sogar ein Anstieg von über 15 Metern bis zum Jahr 2300 nicht mehr ausgeschlossen. Für das Leben auf der Erde hätte dies verheerende Folgen. Schon heute spüre man den Meeresspiegelanstieg im Versalzen von flachen Küstengegenden und in der Zunahme von Schadensflutwellen. Ein messbares Phänomen des Klimawandels ist der Anstieg der global gemittelten Oberflächentemperatur der Erde der letzten 50 Jahre. Im Jahrzehnt 2011 bis 2020 lag jene bereits 1,1 Grad über dem vorindustriellen Niveau (18501900). Dass das Klimaziel von einem Anstieg der global gemittelten Temperatur von maximal 1,5 Grad noch erreichbar sei, sieht der Klimaforscher skeptisch. Dieses Ziel haben sich die unterzeichneten
Länder 2015 im Pariser-Klimaabkommen gesetzt, wohl wissend, dass dies bereits eine große Belastung für die Menschheit bedeute und ein Verfehlen eine noch viel größere Belastung zur Folge hätte. Gleichzeitig verpflichteten sich die Staaten zu konkreten Maßnahmen, um bis 2050 die weltweiten CO2-Emissionen auf netto Null zu verringern. Das Abkommen beinhalte, so Kaser, aber auch, dass bis 2030 der im Jahr 2010 gemessenen Emissionen um 45 % abgebaut werden müssten. Heute seien wir allerdings weit davon entfernt. Bei allen Bemühungen wäre es aber denkbar, das „Parisziel“ bis 2050 zu erreichen, meint Kaser. Dafür müssen aber, neben massiver Eingrenzung der Emissionen von Treibhausgasen schon heute technische Lösungen entwickelt werden, um auch Negativemissionen erzeugen zu können, das bedeutet Treibhausgase aus der Atmosphäre zu entnehmen. Aktuell gibt es eine Reihe von möglichen Ansätzen, die aber einerseits sehr energieintensiv und teuer sind, andererseits noch nicht im benötigten Maßstab einsetzbar sind. Aber auch auf die sogenannten CO2-Budgets kam Kaser in seiner Präsentation zu sprechen. Damit führte er den Zuhörern eine traurige Bilanz vor Augen. Laut Kaser emittieren Herr und Frau Südtiroler im Jahr nämlich pro Kopf rund 5,3 Tonnen CO2. Wenn diese Tendenz weiter so anhält, hätten wir unser persönliches Emissionsbudget bis 2027 verbraucht. Ein Grund mehr, weshalb der Klimaforscher vom Ausbau der privaten E-Mobilität abrät. Bei einer durchschnittlichen Emissionsrate von 26 Tonnen, die bei der Herstellung eines Elektroautos zustande kommt, würde man schon beim Kauf sein gesamtes Lebensbudget verbraucht haben. Kasers Devise lautet deshalb: „Noch vorhandene
Emissionsbudgets müssen genutzt werden, um damit eine emissionsfreie Zukunft zu bauen!“ Ein Konzept, das weltweit schon heute einige Städte und Regionen verfolgen. Als Vorreiter in Europa nennt Kaser die Stadt Kopenhagen, die in ihrer Städteentwicklung bereits wesentliche Akzente setzt. „Je früher wir beginnen Emissionen zu verringern, umso länger reicht das Klimabudget aus.“, erklärt Kaser. Um uns im Burggrafenamt in Zukunft vor möglichen Hitzewellen zu schützen, empfiehlt der Klimawissenschaftler pragmatisch 50 % der Auwälder im Etschtal zu renaturieren. Insgesamt müsste aber auch unser aller Energiekonsum auf die Hälfte zurückgeschraubt werden. Das bedeute aber nicht ein Verzicht, sondern die Rückkehr zu einer gesunden Lebensweise. In seinem Fazit bringt Georg Kaser nochmals in aller Deutlichkeit zum Ausdruck: Es brauche in allen gesellschaftlichen Bereichen ein radikales Umdenken. Ein knappes Handlungsfester sei noch offen, um das 1,5°C Ziel zu erreichen. Aufs Gutewohl zu hoffen, das könne er sich als Klimaforscher nicht mehr leisten. Er sei aber davon überzeugt, dass, wenn wir als Gesellschaft die Nachhaltigkeitsziele der WHO ernst nehmen, wir mit ziemlicher Sicherheit langfristig eine globale Besserung bewirken können.
Philipp Genetti Georg Kaser, sowie Univ. Professor in Ruhestand aus Meran lud gemeinsam mit dem Bildungsausschuss Dorf Tirol unter diesem Motto zum Informationsabend ein. „Klimawandel – Klimakrise – Klimakatastrophe: Die Handlungsfenster schließen sich.“ Klimaforscher Georg KaserJuli 2023 und 30. November 2023 fällig sind. Die verbleibende Schuld wird auf 16 gleich hohe Raten aufgeteilt und ab 2024 eingehoben, mit folgenden Stichtagen: 28. Februar, 31. Mai, 31. Juli, 30. November.
Um von dieser Möglichkeit Gebrauch zu machen, ist innerhalb 30. April 2023 ein eigener Antrag bei der Steuereinhebungsstelle einzureichen. Bis 30. Juni 2023 stellt die Steuereinhebungsstelle dem Steuerschuldner eine Übersicht der zu zahlenden Beträge und einen eventuellen Ratenplan zur Verfügung.


Im Entwurf zum Haushaltsgesetz 2023 ist eine Neuauflage der „Verschrottung“ von Steuerzahlkarten vorgesehen, sowie eine Annullierung von überfälligen Schuldbeträgen bis zu 1000 Euro.
Die Regierung plant im neuen Haushaltsgesetz mehrere neue Maßnahmen mit der Bezeichnung „Frieden mit dem Fiskus“. So ist eine automatische Annullierung zum Datum 31. Jänner 2023 aller offener Schuldbeträge bis zu einem Betrag in Höhe von 1000 Euro vorgesehen. Diese gilt für Steuerrollen, welche der Steuereinhebungsstelle im Zeitraum 2000 bis 2015 übertragen wurden. Des Weiteren ist eine vierte Neuauflage der „Verschrottung“ von bestehender Steuerzahlkarten vorgesehen, dies gilt für Steuerrollen, welche der Steuereinhebungsstelle im Zeitraum 1. Jänner 2000 bis 30. Juni 2022 übertragen wurden. Dabei ist es möglich, die Schuldbeträge ohne Strafen, Zinsen und Verzugszinsen zu bezahlen, somit die reine ursprüngliche Steuerschuld. Die Zahlung kann in bis zu 18 Raten erfolgen, wobei die ersten beiden Raten je 10 % der Steuerschuld betragen, und am 31.
Weitere Friedensangebote beziehen sich z. B. auf die Berichtigung von Formfehlern, welche keinen Einfluss auf die Steuerhöhe haben. Diese können mit einer pauschalen Verwaltungsstrafe in Höhe von 200 Euro pro Jahr saniert werden. Die Fehler oder Unterlassungen müssen jedoch berichtigt werden. Automatisierte Kontrollen betreffend Steuererklärungen der Steuerperioden 2019, 2020 und 2021 können mit einer begünstigten Strafe von 3 % abgefunden werden. Für Festsetzungsbescheide wird eine erleichterte Abfindung mit reduzierter Strafe von 5 % vorgesehen.
Laufende Steuerstreitverfahren können ebenfalls begünstigt abgefunden werden. Der Abfindungsbetrag hängt davon ab, in welcher Phase sich das Steuerstreitverfahren befindet und wer bis jetzt vom Steuergericht Recht bekommen hat.
Bis zur endgültigen Verabschiedung des neuen Haushaltsgesetzes können sich jedoch noch Änderungen ergeben.Insgesamt bieten sich interessante Möglichkeiten zur Abfindung von offenen Posten mit dem Fiskus.

in unserem Restaurant verwöhnen wir Gäste von Klein bis Groß.




Vom herzlichen Willkommensgruß bis zu den herzhaften, leckeren Gaumengenüssen, die der Chef persönlich in seiner Küche zaubert.


Speziell in den Wintermonaten immer von Mittwoch bis freitags.

Eine Wanderung im Trudner-Horn-Naturpark, die von Meran aus gut mit öffentlichen Verkehrsmitteln machbar ist. Von der Haltestelle Pausa aus über Truden zum Sonnenparadies „Cisloner Alm“ und weiter zum Jägerkreuz.
von Christl FinkAnfangs Dezember fahren wir mit dem Zug bis Auer. Direkt vom Bahnhof aus bringt uns der Bus 140, der nach Cavalese fährt, zwischen Kalditsch und Kaltenbrunn zur Haltestelle Pausa beim gleichnamigen Hotel/Restaurant. Dort starten wir.
Am Hotel/Restaurant vorbei geht es der Straße entlang, bis wir zu den Hinweisschildern kommen, die rechts in den Wald hinaufführen. Wir wandern, immer gut auf die Markierung 11 achtend, mäßig steil aufwärts. Sobald wir auf den Zufahrtsweg zum Pausahof kommen, halten wir uns links, dann sehen wir auch schon das Viadukt der ehemaligen Bahntrasse ins Fleimstal. Wieder bergauf und schon sind wir auf dem „Bahnweg“ mit den Hinweisschildern.
Noch ein Stück müssen wir durch den Wald, dann öffnet er sich und wir kommen zu einer Wiese. Am oberen Waldrand entdecken wir bereits Wegweiser und nun zieht sich ein breiter Weg gemächlich nach links und wieder aufwärts.
An einem mächtigen Kreuz vorbei kommen wir zur Straße, die von Kaltenbrunn nach Truden führt, gehen sie kurz entlang und nehmen nicht den Weg, der hinunter in die Dorfmitte führt, sondern biegen gleich rechts ab „in der Granz“ und in die Prophetengasse hinein. Wir gehen sie bis zum Ende, wo der Asphalt endet, sind Tisch und Bänke mit einer herrlichen Sicht über das sich in eine Mulde zwischen dem Ziss-Sattel und dem Trudner Horn im Osten und dem Cislon im Westen
schmiegende Bergdorf. In der gleichen Richtung weitergehend, umrunden wir auf Markierung 3 Truden von oben und erreichen die Straße, die zur Cisloner Alm führt.

Nun geht es ein Stück die Straße aufwärts. Nachdem wir an einem wieder errichteten Kalkofen und einem Marterle vorbeigekommen sind, zweigt bald linkerhand der Wandersteig zur Alm ab. Erst verläuft er eben und leicht abfallend, zwischen Laubbäumen hindurch, die den Steig mit einem wunderbar weichen Teppich aus Blättern bedeckt haben. An der Tafel „Bockbrunnen“ vorbei queren wir eine Rutschung und bald geht es durch ein Gatter kurz einen Wiesenhang hinauf. Nun stehen wir wieder auf der Zufahrtsstraße zur Alm, die wir an Tisch und Bank vorbei in
wenigen Minuten erreichen. Malerisch liegt ein kleiner Weiher unter uns und die erst vor einigen Jahren neu wieder aufgebaute Hütte erhebt sich vor uns.

Das Ziel noch nicht erreicht
Noch ist die Hütte gesperrt, sie öffnet jedoch kurz vor Weihnacht wieder für Hungrige und Durstige. Trotzdem sonnen sich viele Wanderer auf der großen Terrasse. Zum Glück haben wir in weiser Vorahnung bereits zuvor unsere kleine Rast gemacht. Wir gehen oberhalb der Alm den breiten Forstweg in dieselbe Richtung weiter, doch bald zweigt bergwärts unser, mit 3 markierter Steig ab. Hier im Wald ist der Schnee schon liegen geblieben. Der Steig wird zum Weg, zieht sich fast eben nach rechts, bis wir, der Markierung folgend, den bequemen Weg verlassen und nach links aufwärts müssen. Nochmals ein kurzes Steilstück, dann breitet sich vor uns ein verträum-
ter Lärchenwald aus, den wir durchqueren und auf einen Forstweg kommen. Nun geht es in ebener Wanderung nach rechts weiter.

Ganz plötzlich steht das Jägerkreuz vor uns. Hier halten wir eine ausgiebige Rast. Vor uns erhebt sich in Richtung Fleimstal die herrliche Lagoreikette, bereits im weißen Wintermantel, während unser Weg eher spätherbstlich anmutet. Links grüßen das Schwarz- und Weißhorn. Wenige Minuten unterhalb finden wir eine Aussichtsplattform, die „Leger“, mit Kreuz, Tisch und Bänken. Wieder zurück wenden wir uns nun nach rechts abwärts. Ein guter Weg, der weiter unten noch der schöne, alte Pflasterweg geblieben ist, bringt uns zurück zum Scheitel von Truden. Wir wandern die schmale Dorfstraße hinunter zur Kirche, die dem hl. Blasius geweiht ist. Hinter dem Friedhof führen Stufen direkt zur Haltestelle
bringt.
Ausgangspunkt: Hotel Restaurant Pausa, Fleimstaler Straße
Ziel: Cisloner Alm, Jägerkreuz und Truden

Gehzeit: insgesamt rund 2,40 bis 3 Std. Pausa > Trudner Sattel: 40 Min.> Cisloner Alm: 1 Std. > Runde übers Jägerkrereuz nach Truden: 1 Std. Beste Zeit: alle Jahreszeiten, im Winter evtl. mit Schneeschuhen Besonderheit: Das Naturparkhaus in Truden ist bei freiem Eintritt vom Frühjahr bis Spätherbst geöffnet und sehr sehenswert.

 vom Bus 144, der uns zum Bahnhof von Neumarkt
Der KalkbrennofenBlick auf Truden
Der Weiher bei der Cisloner Alm
vom Bus 144, der uns zum Bahnhof von Neumarkt
Der KalkbrennofenBlick auf Truden
Der Weiher bei der Cisloner Alm
WARMHERZIGE, 51 JAHRE ALT, ist feinfühlig, aufgeschlossen, sehr naturverbunden, sucht einen ehrlichen sowie romantischen und humorvollen Mann.

AUSGEGLICHENE, 56 JAHRE ALT, ist tolerant, verständnisvoll, tiefgründig sowie weltoffen, sucht einen gepflegten, niveauvollen und feinsinnigen Nichtraucher.
TANZFREUDIGE, 58 JAHRE ALT, ist sonnig, positiv, ausgeglichen sowie unternehmungslustig und liebt das Tanzen, sucht tanzfreudigen Lebensgefährten.
LIEBENSWERTE, 58 JAHRE ALT, ist geduldig, unabhängig, liebt Kultur, Reisen sowie das italienische Flair und sucht einen tiefgründigen Lebenspartner.

MERANERIN, 59 JAHRE ALT, hat Ausstrahlung, ist fesch sowie selbstständig, möchte sich fallenlassen und am liebsten in die Arme eines gebildeten Mannes.

ANGESTESTELLTER, 30 JAHRE ALT, hat das Alleinsein satt; ist unkompliziert sowie bescheiden und sucht eine sympathische Partnerin mit Kinderwunsch.
BOZNER, 37 JAHRE ALT, mag die Zweisamkeit, die Gemütlichkeit, die Natur die Vertrautheit zu Hause, sucht eine liebevolle und ausgeglichene Lebenspartnerin.
NATURVERBUNDENER, 48 JAHRE ALT, sehnt sich nach Familie und Partnerschaft. Wünscht sich eine Frau die das Landleben mag und gleichzeitig Schwung hat.
VINSCHGER, 56 JAHRE ALT, mag gemütliche Spaziergänge, Sightseeing und gutes Essen; ist spontan, flexibel, gesellig, sucht eine aufgeschlossene Sie.

SELBSTBEWUSSTER, 51 JAHRE ALT, ist gutaussehend, erfolgreich sowie emotional gefestigt, sucht charismatische Frau, gerne jünger und mit Kinderwunsch.
39012 Meran I L.-Zuegg-Str. 28/A I Tel. 0473 200790 I info@herzblatt.it I www.herzblatt.it
Biete Fußpflege im Raum Meran und Umgebung, auch Hausbesuche. Tel. 347 900 63 08








Wir suchen einen Leiter unseres Reinigungsteams (m/w/d) in Nals.











Du hast große Freude an dem, was du tust, hast Spaß am Organisieren? Du trägst gern Verantwortung, leitest und motivierst dein Team und magst es einfach gern sauber und ordentlich? Hast HACCP, die Sauberkeit aller Anlagen und Räume gut im Blick? Dann tanz mit uns! www.meinbeck.it/jobs
Tanja mit Team wünscht allen Kunden frohe Festtage und einen guten Rutsch in das neue Jahr.


Wir bedanken uns für das entgegengebrachte Vertrauen.

Wir beraten Sie gerne! Tel. 339 10 70 714 www.zahnarzt-ungarn-heviz.de
Wir suchen ab Mitte März 2023 für eine lange Saison:
Chef de Partie (m/w) (D) Kochlehrling (m/w) (D) 2. Lehrjahr Service-Mitarbeiter (m/w) mit Weinkenntnissen (D/I/E) Housekeeping-Mitarbeiter (m/w) 7.30 – 16.00 Uhr Bewerbungen an job@hotelmignon.com Tel. 0473 230 353



Verkäufer/in (Vollzeit) Vitaplus Meran
Wir freuen uns auf Ihre Bewerbung an: job@ladurner.com
Sekretärin m/w, deutsch- und italienischsprachig gesucht. Tel. 345 0468069, E-Mail verwaltung@pircher-r-com






Tel. 0471 978 875
Tel. 00421 907953712 www. agenturgrant.com




















